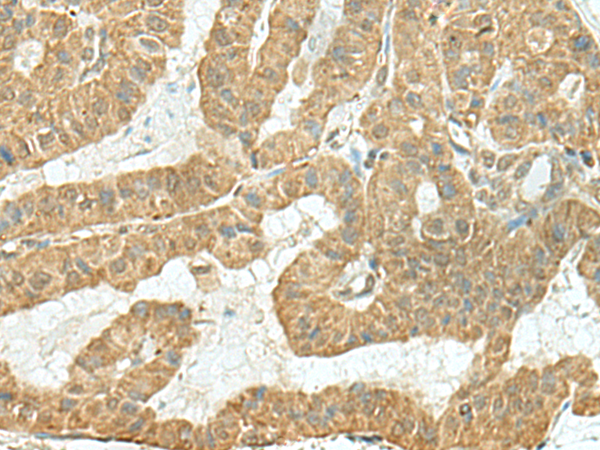
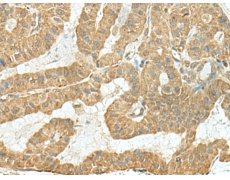
一抗

|
Background: |
Probable nucleotidyltransferase that may act as a non-canonical poly(A) RNA polymerase. (Microbial infection) Seems to enhance replication of some viruses, including yellow fever virus, in response to type I interferon. |
|
Applications: |
ELISA, IHC |
|
Name of antibody: |
TENT5C |
|
Immunogen: |
Fusion protein of human TENT5C |
|
Full name: |
terminal nucleotidyltransferase 5C |
|
Synonyms: |
FAM46C |
|
SwissProt: |
Q5VWP2 |
|
ELISA Recommended dilution: |
5000-10000 |
|
IHC positive control: |
Human thyroid cancer |
|
IHC Recommend dilution: |
150-300 |
購物車
購物車 幫助
幫助
 021-54845833/15800441009
021-54845833/15800441009